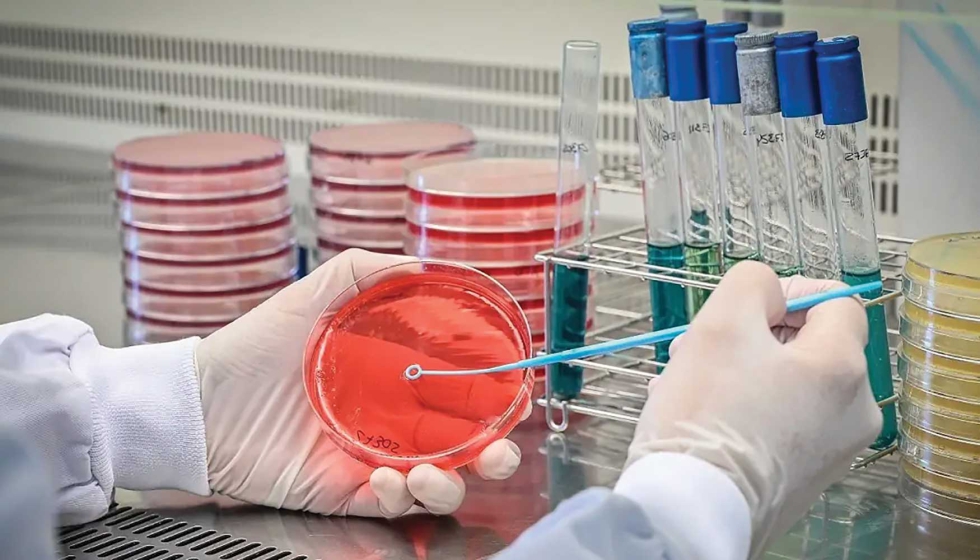
Imagen

Desafíos en la detección de bacterias patógenas en estado viable pero no cultivable (VBNC) en la industria alimentaria
El estado viable pero no cultivable (VBNC, por sus siglas en inglés Viable But Non-Culturable) en bacterias patógenas transmitidas por alimentos, como Salmonella spp. y Listeria monocytogenes, está cobrando relevancia en la actualidad debido a su capacidad de evadir los controles microbiológicos oficiales y suponer un riesgo emergente para la seguridad alimentaria y la salud. A través del proyecto VBNC-PATHOGENS, en Ainia buscan profundizar en los procesos productivos susceptibles de inducir el estado VBNC en la industria alimentaria y de desarrollar metodologías específicas de detección de estos patógenos.
Las enfermedades transmitidas por microorganismos patógenos alimentarios continúan siendo un importante problema de salud pública y seguridad alimentaria a nivel mundial. A pesar de los controles microbiológicos establecidos por el Reglamento (CE) 2073/2005 y la vigilancia del sistema RASFF, en 2023 las alertas por patógenos representaron la segunda categoría de peligro más común en los alimentos (856 notificaciones), destacando Salmonella spp., Listeria monocytogenes y Escherichia coli.
Según la EFSA, los brotes alimentarios aumentaron un 43,9% en 2022 respecto a 2021, junto con un incremento en la mortalidad asociada. En 2024 se notificaron 561 casos de Salmonella spp. y 161 de Listeria monocytogenes, principalmente en productos cárnicos, pescados, lácteos, frutos secos y semillas, algunos considerados de bajo riesgo por su baja actividad de agua. Estos datos evidencian la necesidad de desarrollar nuevas metodologías que permitan una detección más precisa de microorganismos patógenos viables en la cadena alimentaria.
El estado viable pero no cultivable (VBNC) presenta un gran desafío. Se trata de un estado fisiológico de latencia en el que ciertas bacterias se encuentran metabólicamente dormidas y son incapaces de crecer en medios de cultivo convencionales. Esto se traduce en que pasan desapercibidas en los controles oficiales microbiológicos, basados principalmente en el aislamiento en medios de cultivo selectivos y ejecución de recuentos en placa, pudiendo con ello, incorporarse en la cadena alimentaria, y siendo un riesgo para la salud del consumidor.
Hasta la fecha, se han identificado 85 especies de bacterias que pueden entrar en el estado VBNC, incluidas 67 especies patógenas como Staphylococcus aureus, Escherichia coli, Salmonella y Listeria monocytogenes, entre otras. Estas bacterias representan un peligro considerable y oculto en la evaluación de la inocuidad alimentaria.
Factores susceptibles de inducir el estado VBNC en la industria alimentaria
El estado VBNC es una estrategia de supervivencia que emplean ciertas bacterias para resistir frente a distintos factores de estrés ambiental, como la privación de nutrientes, el estrés oxidativo o las bajas temperaturas.
En el contexto de la industria alimentaria, existen numerosos factores que pueden llegar a inducir el estado VBNC durante el procesamiento y almacenamiento de alimentos. Estos factores pueden ser de naturaleza química (por ejemplo, algunos reactivos químicos que se utilizan comúnmente en el proceso de procesamiento de alimentos, como la adición de conservantes para prolongar su vida útil, o el uso de desinfectantes en plantas y equipos de procesamiento) o física (por ejemplo, la temperatura, tratamientos de secado, irradiación con luz ultravioleta, tratamientos con campo eléctrico pulsado y luz pulsada, dióxido de carbono a alta presión, tratamientos con plasma, entre otros).
Factores que pueden inducir la reactivación de patógenos VNBC
La reactivación de bacterias VBNC, también conocida como resucitación, se refiere al proceso mediante el cual estas bacterias, que han perdido la capacidad de crecer en medios de cultivo convencionales, recuperan su actividad metabólica y la capacidad de multiplicarse y proliferar, volviendo a un estado cultivable y, por tanto, patogénico. Cabe destacar que, en numerosas ocasiones, las condiciones idóneas para la reactivación al estado patogénico se dan en el interior del organismo, pudiendo desencadenar intoxicaciones alimentarias graves.
Los principales factores susceptibles de reactivar a bacterias VBNC son:
- Aumento en la concentración de nutrientes: la adición de medio rico es uno de los primeros métodos utilizados para resucitar bacterias VBNC.
- Cambios de temperatura: tanto el aumento como la disminución de la temperatura puede desencadenar la reactivación, especialmente en bacterias inducidas al estado VBNC por temperaturas extremas.
- Estímulos químicos: algunos compuestos químicos pueden promover la reactivación, como el piruvato de sodio o la adición de aminoácidos.
- Estímulos biológicos: el cocultivo con otras especies bacterianas o incluso con algunas levaduras se ha observado que puede inducir la reactivación en ciertas especies. También proteínas como las Rpf (Resuscitation promoting factor) o ciertas moléculas de señalización de quorum sensing juegan un papel crucial.
Metodologías para la detección de bacterias en estado VBNC
Dado que en el estado VBNC las bacterias pierden su capacidad de proliferar, no pueden detectarse mediante los métodos de cultivo tradicionales, que son los que marca la normativa europea. Como alternativa, los métodos siguientes podrían ser de gran utilidad a la hora de detectar la presencia de bacterias vivas, independientemente de si son cultivables o no:
- Métodos basados en biología molecular: se basan principalmente en la técnica de la PCR (Polymerase Chain Reaction) con adaptaciones para la detección específica de células viables. Por ejemplo, la técnica PMA-qPCR utiliza unas moléculas especiales que se unen al ADN de las bacterias muertas y bloquean su amplificación por PCR, de forma que sólo se detectan las bacterias vivas de una muestra.
- Citometría de flujo: permite estudiar y clasificar células individuales en suspensión mediante el uso de un láser y detectores ópticos. Permite diferenciar entre células vivas y no vivas por medio del uso de ciertos colorantes fluorescentes.
- Tecnologías ómicas: permiten evaluar la viabilidad de las células al analizar su actividad biológica, como la expresión génica y las rutas metabólicas activas. Entre sus principales ventajas destacan la alta sensibilidad, la capacidad de detectar múltiples especies simultáneamente y la obtención de información global sobre metabolismo y expresión génica.
Proyecto VBNC-PATHOGENS
En el marco del proyecto VBNC-PATHOGENS, en Ainia quieren identificar los procesos productivos de la industria alimentaria que pueden inducir el estado VBNC y su posterior reactivación al estado patogénico. Además, trabajan en el desarrollo de soluciones tecnológicas para la detección de bacterias VBNC transmitidas en la cadena alimentaria, principalmente Salmonella spp. y Listeria monocytogenes.
El objetivo de Ainia es proporcionar a las empresas de la Comunitat Valenciana herramientas para evaluar el riesgo e incidencia de estas bacterias en sus alimentos y procesos, así como para comprobar la eficacia de sus métodos y productos de limpieza y desinfección. Para ello, cuentan con la colaboración de tres empresas del sector alimentario y una empresa especializada en higiene industrial.
Este proyecto constituye un proyecto de I+D+i de carácter no económico vinculado al programa de I+D de un Centro Tecnológico de la Comunitat Valenciana en colaboración con empresas y financiado por IVACE+i.







